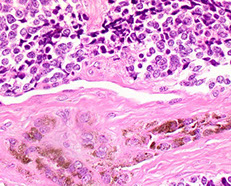

Salivary Glands
Anatomy / Histology
Malignant Salivary Gland Tumors
Development and Growth
Definition of Salivary glands
Classification
Anatomy
Histology
Inflammatory Salivary Disease
Xerostomia
Lymphoepithelial Cysts
Sialadenitis
Sialometaplasia
Necrotizing Sialadenitis
- Subacute necrotizing sialadenitis
- Necrotizing sialometaplasia
Adenomatoid hyperplasia
Mucocoele
Benign Salivary Gland Tumors
Pleomorphic adenoma (mixed tumor)
- Monomorphic adenoma
- Myoepithelioma
Papillary Cystadenoma Lymphomatosum (Warthin tumor)
Oncocytoma
Oncocytosis
Basal cell adenoma
Canalicular adenoma
Ductal papilloma
Sebaceous lymphadenoma
Mucoepidermoid Carcinoma (MEC)
Adenocarcinoma NOS
Basal Cell Adenocarcinoma
Acinic Cell Carcinoma
Adenoid Cystic Carcinoma
Epithelioid-Myoepithelioid Carcinoma
Myoepithelial carcinoma
Sialoblastoma
Squamous Cell Carcinoma
Salivary Duct Carcinoma
Polymorphous low-grade adenocarcinoma (PLGA)
Mammary Analogue Secretory Carcioma (MASC)
Low-grade cribriform cystadenocarcinoma
Small cell carcinoma (see Salivary Gland Cytology)
Oropharynx and Teeth
Pigmented (Melanocytic) Neuroectodermal Tumor of Infancy
Mucocele
Squamous papilloma
HPV Positive OP Ca
Ameloblastoma
Dentigerous Cyst
Adenomatoid Odontogenic Tumor (AOT)
Calcifying Odontogenic Cyst
Keratocystic Odontogenic Tumor (KCOT)
Ameloblastic Carcinoma
Anatomy / Histo of Salivary Glands
Development [1]
Parotid and submaxillary: primordium formed at 5-6 WGA
Sublingual: primordium formed at 7-8 WGA
Minor glands: primordium formed at 11-12 WGA
Growth
1. Stimulated by factors found in the mesenchyme
2. Innervation stimulates growth
3. Chronically increased stimulation (ie by inc food bulk) stimulates growth of glands
Definition
Salivary glands are exocrine glands that secrete saliva into the oral cavity
Classification
- can be by size and / or secretion
Size classification:
Major salivary glands - 3 pairs
- 2 parotids / encapsulated, Stenson's Duct / Parotid papillae
- 2 submaxillary / Sub-encapsulated, Wharton's duct - mandibullary gland
- 2 sublingual glands / non-encapsulated, no single major duct (Bartholin's duct?), Sublingual caruncle
Minor salivary glands
- labial and buccal
- glossopalatine and retromolar pad area
- palatine
- lingual
Minor glands that secrete mostly Mucous
- von Ebner glands - serous: circumvallate and foliate papillae
- Blandin and Nuhn - Mucous: midline ventral tongue mostly towards tip
According to Secretion
- pure serous (Parotid)
- pure mucous (Sublingual)
- Seromucous (Submaxillary)
Anatomy
Parotid gland
Largest salivary gland; located in the triangle surrounded by the zygomatic arch superiorly, the masseter anteriorly, and SCM posteriorly
- inferior pole mostly confined to angle of the mandible
- medial pole mostly confined to the TMJ
- protid duct (Stenson's duct) leaves the anterior border, passes anteriorly on the masseter, penetrates the buccinator and opens into the buccal cavity
- facial nerve (CNVII) penetrates the gland
Sublingual gland
- found superior to the myohyoid
- superior border of the sublingual gland appears as the sublingual fold in the oral floor
- superior border of sublingual gland appears as the sublingual fold in the oral floor
- major sublingual duct (Bartholin's duct) opens in the sublingual caruncle
- numerous minor sublingual ducts on the sublignual fold
Submandibular gland
Located in the inferior space of the myohyoid
- the submandibular duct (Wharton's duct) runs forward along the lingual nerve in the sublingual space and opens into the sublingual caruncle
Linguaal gland - Mucous and serous glands
Mucous glands
Similar in structure to the labial and buccal glands. They are found especially at the back part behind the vallate papillae, but are also present at the apex and marginal parts. In this connection the anterior lingual glands (Blandin or Nuhn) require special notice. They are situated on the under surface of the apex of the tongue, one on either side of the frenulum, where they are covered by a fasciculus of muscular fivers derived from the Styloglossusus and Longitudinalis inferior. They are from 12 to 25 mm long, and about 8 mm broad, and each pens by three or four ducts on the under surface of the apex
Serous glands (von Ebner's gland)
occur only at the back of the tongue in the neighborhood of the tast-buds, their ducts opening for the most part into the fossa of the vallate papillae. These glands are racemose (clustered), the duct of each branching into several minute ducts, which end in alveoli, lined by a single layer of more or less columnar epithelium. Their secretion is of a watery nature, and probably assists in the distribution of the substance to be tasted over the taste area
Histology
Submandibular gland
Mixed salivary gland, predominantly serous acini, some mucous acini with serous demilunes
- short intercalated ducts, and striated ducts c simple cuboidal lining epithelium
- interlobular ducts c stratified cuboidal or stratified columnar epithelium surrounded by connective tissue
Sublingual gland
Mixed salivary gland, c predominantly mucous acini; some serous demilunes
- acini are composed of centrally-located mucous cells and peripheral serous demilunes
- short intercalated ducts, striated ducts c simple columnar lining epithelium
- interlobular ducts c stratified cuboidal / columnar epithelium surrounded by connective tissue
Parotid gland
Serous salivary gland, serous acini, zymogen granules, intercalated ducts, striated ducts, interlobular ducts c stratified epithelium, lobules c connective tissue septa and nearby LN c capsule







Inflammatory Salivary Disease
Xerostomia
- aka dry-mouth
Common side-effect of meds, esp in elderly population
Assoc c Sjogren's syndrome
May cause mouth sores and tooth cavities
Lymphoepithelial Cyst
Occur in LNs in parotid, around the parotid, lacrimal glands or cervical areas
- may be a consequence of HIV infection
Micro: Reactive epithelial cells ("epithelial-myoepithelial islands") surrounded by heavy inflam
- these epithelial cells are ectopic tissue possibly derived from the branchial pouch
Branchial cleft cysts, Hashimoto's thyroiditis and multilocular thymic cysts can have similar etiology
Sialadenitis
Inflammation that may be caused by a number of factors (trauma, infx, autoimmune)
MC type of lesion in sialadenitis is a mucocele
- Mumps is the MC viral cause of sialadenitis
Mucocele
MC lesion of the salivary glands, usually found on bottom lip as a results of trauma, and may have a bluish tinge to them
- can be caused by a blockage or rupture in the ducts
Micro: have cystic spaces filled c mucin and lined by inflam cells
Tx: Complete surgical excision (will recur if not completely excised)
Ranula - mucocele of the sublingual glands
- may grow into a "plunging ranula" - a cyst so large it busts through muscle tissue of the jaw
Sialometaplasia
Nests of reactive epithelial cells in pre-existing salivary tissue which is a reaction to damaged tissue
- see uniform round/spindly cells in acini or intercalated ducts at transition bwt normal and damaged tissue
- not mits or pleomorphism
- necrotizing sialometaplasia may be caused by an ischemic event
Necrotizing sialadenitis
A non-specific inflam condition of unknown etiology affecting oral minor salivary glands
Sx: palatal swelling c abrupt onset of pain
Subacute necrotizing sialadenititis
Diffuse gland involvement; loss of acinar cells; early acinar cell necrosis; atrophy of ductal cells; no ductal squamous metaplasia; no significant fibrosis
Necrotizing sialometaplasia
Lobular coagulative necrosis of acini (glands); ductal metaplasia; PEH of the overlying squamous epithelium; mucous pooling and granulation tissue; fibrosis (inna late lesion)
- squamous metaplasia and hyperplasia of the duct system retains the duct system architecture
- inflam is probably caused by a reaction mucin released by necrotic glands
- is a reactive lesion secondary to infarct of salivary gland tissue, typically on the palate
Px: is a self-limiting condition, the act of the bx usually releases growth factors that lead to resolution
Adenomatoid Hyperplasia
Unknown etiology; seen in both genders of adults
- hard and soft palate see retromolar mass

Lymphoepithelial cyst
Subacute necrotizing sialadenitis of the left palate c focal acinar necrosis (stars)


Subacute necrotizing sialadentiis
Necrotizing sialometaplasia of the palate with pseudoepitheliumatous hyperplasia (PEH)


Salivary Gland Tumor Overview
Benign
Malignant
Benign Salivary Gland Tumors

Pleomorphic adenoma
- aka Mixed Tumor
MC salivary gland neoplasm (~50% of all salivary gland tumors)
- makes sense that they are MC in parotid, bc the larger the salivary gland, the more likely a tumor there will be benign
Presents as a painless, slow-growing, movable mass, usually in the superficial parotid in the tail of the gland
- high rates of recurrence; total parotidectomy should be done to reduce this risk
Gross: round, well-demarcated but often not completely encapsulated and can protrude into surrounding gland (may be a factor in recurrence)
Micro: mix of ductal and ? surrounding myoepithelial cells with varying degrees of ossification, cartilage, myxoid and hyaline tissue present (chondromyxoid)
- may have oncocytic change
- forms "pseudopods", or tongues / outpouchings that may be left behind in excision
- several variants exist: Cellular, Atypical (isolated atypia, vascular tumor plugs and capsular "breaks), Recurrent multinodular, and Benign metastasizing
- tyrosine crystalloids can be seen in stromal component
IHC: (+) ME pos for CK/p63/calponin/SMA/S100/GFAP, epithelium pos for CK/EMA/CEA/c-kit (luminal)
Genes: PLAG1 proto-oncogenere arrangement from 8q12 in ~1/3
- also seen in ST/cutaneous mixed tumors and lipoblastomas
- PLAG1 IHC stain available
- HMGA2 rearrangements
Tx caveat: PAs c lots of mucin may recur more bc sticks to surgical instruments during initial procedure and are innoculated into residual salivary tissue; tend to see multiple tumors in recurrence
Px: Rate that it may develop into a malignant mixed tumor increases with the amount of time it is present (if it does turn malignant, it is very aggressive)
- if turns malignant, called carcinoma ex pleomorphic adenoma or malignant mixed tumor, the probability of turning malignant increases with time (they are the most aggressive salivary gland tumors!!!); and up to 5-10% of PA's can turn into ca ex-PA
Monomorphic adenoma
- per Rosai, the term was originally developed to encompass all benign tumors that are not pleomorphic adenomas (thus including all dx's on this page [Warthins, basal cell adenoma, etc]); but there is confusion that arises from using this term, so just don't dx anything as a monomorphic adenoma ...
Myoepithelioma
B9; a monomorphic adenoma made of just myoepithelial cells
- can be spindled, plasmacytoid, clear cell, epithelioid
- greater % turn malignant than PA's
IHC: (+) S100, calponin, CK5/6
- neg
- don't mistake for SCC


Pleomorphic adenoma
Papillary Cystadenoma Lymphomatosum (Warthin tumor)
2nd MC salivary gland tumor (~10% overall salivary gland tumors)
- MC in male smokers over 50 yo, bilateral (in 1/20?)
- arises from lymph tissue w/in parotid gland and is usually multifocal
Gross: filled c grumous material (from cysts)
Micro: Double layer composed of outer columnar cells and inner cuboidal cells lining reactive (not neoplastic) lymphoid tissue [comes from native lymph tissue of parotid]
- outer layer filled with mitochondria and appears reddish (termed "oncocytic"); the outer epithelial layers are the neoplastic component of Warthin's
- may infarct if becomes too big and have central necrosis
- deprive oncocytes of O2 a little bit and they will infarct, so watch out for reactive changes
- can have "motor oil" background cytologically
***WAR THE NODE (lymph node, that is)***
- WarthiN looks like a lymph Node
Tx: Superficial parotidectomy
- may infarct if untx'd
Px: may rarely transform into a higher-grade tumor

Warthin tumor
Oncocytoma
Rare, solid, parotid, oncocytes polygonal c lots of mitochondria
- absence of fluid, lymphs and debris
- grossly a well-circumscribed tan nodule
Micro: big polygonal cells c lots of red granular cytoplasm, usually has capsule (hence b9)
- may look worrisome if prev FNA'd
IHC: (+) PTAH, c-kit, PAS+/diastase sensitive clear cells,
- neg ME markers
DDx: WT, ACC
Oncocytosis
- aka multinodular oncocytoma, multifocal adenomatous oncocytic hyperplasia
Either parotid cysts lined by oncocytes or well defined clusters of oncocytes
- b9, multifocal / nodular or diffuse prolif of oncocytic cells usually in parotid gland (can be bilateral)
Oncocytoma




Membranous basal cell adenoma
Basal cell adenoma
Basal cell adenoma


Basal Cell Adenoma (BCA)
Several different subtypes (solid, membranous, tubular, trabecular, tubulotrabecular, cribriform), usually older pts, F>M; parotid>>submandibular>>other sites
Micro: 2 cell types: luminal (light) and basal abluminal (dark), and sometimes has peripheral palisading, has basosquamous whorls in center of cellular nests
- all subtypes have fibrous stroma, no cartilage or mucin (as in a PA), and can have cystic change, squamous whorls, keratinization or cribriforming
- membranous subtype has basaloid nests and islands that form jigsaw patterns and are surrounded by a thick hyalinized BM, and can be multifocal and unencapsulated (appearing similar to adenoid cystic ca, but membranous does not have as much atypia or cribriforming) [1]
- if prominent basal layer is lacking, may be difficult to ddx from PA (BCA does not have myxochondroid matrix); may additionally resemble a myoepithelioma if made of entirely myoepithelial cells
IHC: (+) calponin (highlights myoepithelial stromal parts, as in PA)
Genes: CTNNB1 mutations
Tx: total parotidectomy
Px: one quarter recurs and one quarter turns malignant
Canalicular adenoma
B9 epithelial tumor c chains of columnar cells and loose CT stroma, 1/100 salivary gland tumors, esp in upper lip minor salivary glands, F>M, blacks>whites, in 60s (yo)
- grossly is well-circumscribed, no capsule, solid or cystic
Micro: long columnar cell chains that can break up or fuse together in loose collagenous stroma
Px: excellent, rarely recurs
Ductal Papilloma
Group of b9 uncommon epithelial salivary gland neoplasms c unique histology; usually a slow growing painless mass, treated c surgical excision for all subtypes; rarely recur, and malig transformation is rare
Subtypes:
Sialadenoma Papilliferum (SP) – b9 tumor c exophytic (papillary) and endophytic epithelial proliferation of mucosa or salivary duct origin
- occurs mostly in palate (4/5) usually at junction of soft and hard palates; rarely involves major salivary glands
Inverted Ductal Papilloma (IDP) – luminal papillary projection arising at junction of salivary gland duct and oral mucosal surface epithelium c characteristic inverted (endophytic growth) pattern
- usually on lower lip and buccal mucosa
Intraductal Papilloma (IP) - unicystic duct dilatation of luminal papillary proliferation coming from segment of interlobular or excretory duct
- MC in intraoral minor salivary glands
DDx: Mucoepitdermoid carcinoma (MEC) – has characteristic epidermoid cells, mucocytes and intermediate cells, usually c proliferative (thickened) appearance in MEC absent in ductal papillomas; MEC also has invasive features not seen in ductal papilloma, though can still diagnose MEC if invasive features are absent but the 3 characteristic cell types are there
- Papillary cystadenoma (PC): usually a multicystic lesion (vs unicystic in IP); also the intraluminal papillations of IP are more complex and numerous than the papillae of PC
- Verrucous carcinoma (VC) – tiered keratosis is present in VC, absent in SP; ductal component is absent in VC
Inverted Ductal Papilloma - IDP

Cystadenoma
B9 unicystic or multicystic epithelial neoplasm devoid of extraluminal solid growth; primarily in parotid gland and minor salivary glands of lips, buccal mucosa and palate
Micro: Well-circumscrbed but variable encapsulation; cystic spaces of variable number and size; epithelial lining typically composed of cuboidal to columnar cells; intraluminal papillary proliferation may be evident
Tx: conservative surgical excision
Px: recurrence uncommon after complete removal
DDx: MEC, Salivary duct cyst, cystadenocarcinoma, Warthin tumor
Papillary oncocytic cystadenoma

Sebaceous lymphadenoma (SLA)
Rare, b9 lymphoepithelial cyst c sebaceous differentiation
- tumor cells are embedded within a dense benign lymphoid stroma
- Tumors lacking sebocytes are termed non-SLA
- slow-growiing asyptomatic neoplasm almost always in parotid
- made of variably sized and shaped groups of sebaceous cells, salivary ducts and cysts in lymphoid background
Several theories exist as to pathogenesis, possibly from salivary gland entrapped in LN
Cyto: SLA typically exhibits vacuolated cells with microvesicular cytoplasm and indentations around a central nucleus associated with basaloid epithelial clusters within a lymphoid background. However, owing to tumor heterogeneity, diagnostic challenges arise when not all cellular components are present. The lymphoid background remains the most encountered feature, emphasizing the importance of including SLA in the differential diagnosis of lymphoid-rich salivary gland lesions
IHC: epithelial elements express basal cell markers, such as p63 and CK5/6, in an abluminal staining pattern,
- CK7 highlights luminal cells.
- Myoepithelial cells are usually absent or only focally present.
- Cells with sebaceous differentiation, characterized by finely to coarsely vacuolated cytoplasm, can be highlighted by adipophilin.
- Background lymphocytes are polytypic

Sebaceous lymphadenoma
SLA

Malignant Salivary Gland Tumors
Mucoepidermoid Carcinoma (MEC)
MC malignant salivary gland tumor (~15% overall salivary gland tumors)
- MC in parotids, but, as expected from malignant salivary gland tumors they also frequently occur in the smaller salivary glands
Painful, causes numbness and CN VII paralysis, grows fast, causes dysphagia and ipsilat ear drainage
- LG MEC is cystic and has better px, whereas HG MEC is less cystic and has worse px
Micro: as name suggests, is a mix of Mucous-secreting cells (should see goblet cells c lots of intracellular mucin, +/- exctracellular mucin), squames / epidermoid cells and intermediate / basaloid cells
- irregular cellular nests should be invading into normal tissue, and may see some squamous metaplasia / keratinization
- more goblet cells means more differentiated; more intermediate / basaloid cells means, conversely, less differentiated (aka the more mucoid the better, the more solid / squamoid the worse)
-- high grade lesions will necessitate a LN dissection!!
- can have lymphoid infiltrate
- look for sclerotic stroma and tumor assoc lymphoid response (TALP)
- low grade has mucous extravasation phenomenon
IHC (+) EMA, PAS/D (diastase digests glycogen, abundant in tumor cells), p63 (nucleus, in intermediate cells, the stronger the worse), CK7, Ki-67 (higher index the worse), HER2 (cell membrane, higher positivity = higher grade), mucicarmine (goblet cells)
- CK5/6 (rare pos, cytoplasmic, epidermoid > transitional cells),
- neg: ME markers (S-100, calponin, CK20, GFAP)
Genetics: (11;19)(q21;p13) which fuses MECT1(CRTC1)/MAML2 genes found in 40-80%
DDx: Sialometaplasia; Mucus Extravasation Reaction; Squamous cell carcinoma; Clear Cell Malignancy; Cystadenoma; Cystadenocarcinoma
Tx: Excision w/ lymph node dissection if large.
- Rads/ chemo may be used if high stage/ grade
Grading: Low < 5 < Intermediate < 6 < High
+ 2 = intracystic component < 20%; Neural invasion
+ 3 = 4+ mits/HPF; Necrosis
+4 = Anaplasia
Prognosis:
- Low grade has good prog (15% recurrence, 2.5% mortality)
- High grade poor prog (55-80% mets [lung, bone, brain]/mortality)
-- tongue/ mouth floor/ submandibular glands have poor prog regardless of grade/ stage
5-year survival depends on tumor grade and ranges from 50-90%


Adenocarcinoma NOS (AC NOS)
Dx of exclusion, but still ~1/5 of all salivary gland carcinomas, F>M, MC in parotid (3/5), but also in hard/soft palates, buccal mucosa, and lips
- present as slow growing painless mass, can extend to underlying bone, grossly can have hemorrhage or necrosis and can be circumscribed or infiltrative
Micro: ductal structures c infiltrative growth
- can look pretty tame in low-grade AC NOS
- cribriform pattern is low-grade, called cribriform AC of minor gland origin
IHC: nothing chaacteristic
Cyto: difficult, can try to differentiate low and high grade
Genes: Cribriform adenocarcinoma assoc c PRKD rearrangement
Px: grade, stage and location dependent (better in minor glands)
- 15 yr survival ranges from 1/2 to 1/50 from low to high grades
Basal Cell Adenocarcinoma (BCAC)
- aka basaloid carcinoma
Rare (1/50 salivary gland tumors), partially encapsulated, similar cells as BCA, but invades (nerves, vessels and stroma), and has higher Ki67 (>5%) / high mits (>4-5/10 hpf)
- is not equivalent to malignant transformation of basal cell adenoma
Prominent palisading within nests
- can have nests of matrix material within the nests
Acinic Cell Carcinoma
Malignant neoplasm with cells resembling normal serous acinar cells;
Parotids(4/5) > Submandibular > Minor salivary glands, F>M
May be bilateral or multicentric (like Warthin’s)
Tumors are generally small discrete lesions
- there is no b9 counterpart (acinic cell adenoma)
- grossly firm, circumscribed most of the time
Variable architecture (types) and cell morphology
Clear cytoplasm generally, but can be solid or vacuolated
- if cytoplasmic vacuoles present, may stain PAS (+); however they are just secretory granules and not mucin (as in MEC)
- usualy basophilic c lots of lymphoid infiltrate
- can look a little like thyroid
Can be in sheets or microcystic, glandular, follicular or papillary patterns
Usually few mitoses and little anaplasia
IHC: (+) PAS, PASD, (clear cells are PAS and mucin neg), keratin, amylase, transferrin, IgA, proline-rich protein, ANO1 (anoctamin-1)/DOG1 (Discovered On GIST-1), SOX10
- Negative GCDFP-15, MUC1, BRST-2 and mammaglobin and HER2
Clinical course dependent of degree of pleomorphism, though not well established
10-15% with LN mets, up to 35% recurrence
Both associated with worse prognosis
- otherwise fairly good 5-year survival (low-risk)
Acinic cell carcinoma

Adenoid Cystic Carcinoma
- aka cylindroma
~1/15 of all salivary gland tumors; seen in older women
- mostly (60%) seen in minor salivary glands, esp in the palate; (MC malignant tumor of minor salivary glands)
Have extensively invasive growth patterns, esp perineural invasion
Micro: Biphasic c ductal lining and ME cells with cribriform, tubular or solid pattern and hyaline material filling the spaces bwt tumors (stromal hyalinization [thick BM])
- usually contains at least some cribriform nests (Swiss cheese) filled c myxoid (blue goo), but may not be present on small bx
- tumor cells should not have intracytoplasmic mucin (found in MEC) - mucin is secreted into pseudocysts - also shound not have squamous metaplasia
- considered high-grade if >30% has solid growth pattern - has calcification / comedonecrosis in high grade
Cytology: carrot-shaped
Genes: LOH at 6q23-35, MYB-NFIB in 1/2
IHC: (+) ME pos for CK (lumen epithelial cells) / p63 (basal-myoepithelial cells) / calponin / SMA / S100 / GFAP, epithelium pos for CK/EMA/CEA/c-kit (luminal) and CD117???
DDx: PLGA (PLGA has less mits, less hyperchromasia, less dense fibrous stroma, smaller nests and less nuclear polymorphism); PA
Tx: Radical excision and rads
Px: Tend to recur and met; thus are high risk and have relatively low 5- and 10-year survivals (MC mets to lung)
- high tendency for perineural invasion
Adenoid cystic ca



High grade adenoid cystic ca c comedo necrosis
Epithelial-Myoepithelial carcinoma
Rare (<1% of salivary tumors) cancer c biphasic ductoid structures c inner layer of duct lining, epithelial cells, and outer layer of clear myoepihlium-type cells
- in parotid in older pts (7th decade), usually low grade (though can be high grade) c both epithelial and myoepithelial parts
- aka glycogen-rich adenoma
Gross: ~2.5 cm, tough, well-circumscribed but not encapsulated, sometimes lobulated
Micro: low grade with double-layered duct-oid structures (inner cuboidal duct-lining cells and outer myoepithelial layer[s] c clear cytoplasm and eccentric nuclei), multinodular
- mild nuclear pleomorphism, varialble mits
Cyto: cellualr, single cells c naked nuclei
- might not see both cell types
IHC: (+) ME pos for CK/p63/calponin/SMA/S100/GFAP, epithelium pos for CK/EMA/CEA/c-kit (luminal)
Px: thought to be b9 (4/5 5-yr survival), but can have mets
- worse if high mits, inc atypia, and aneuploidy
epithelioid-myoepithelioid ca


Myoepithelial carcinoma
- aka malignant myoepithelioma
tumor made almost entirely of myoepithelial cells, mostly in parotids, M=F
- grossly uncircumscribed
Micro: multinodular c infiltration into adjacent tissues
- nodules are solid and in sheets c lots of mcous and sometimes central necrosis, can have variable histology
- nuclei can range from relative calm looking to ramped up, and can have few to lots of mits
- 1/2 have perineural invasion
- no true glands or lumina seen
IHC: (+) S100 (all have some degree of staining), myoepithelial markers (muscle-specific actin, GFAP, CD10, calponin, smooth muscle myosin heavy chain), CK, glycogen, Alcian blue (in myxoid matrix), p63 (3/5), smooth muscle actin (3/5),
- neg: mucicarmine (if doesn't have glands)
Px: 1/3 of pts die of the dz, 1/3 get recurrences and 1/3 dz free
Sialoblastoma
Rare, sometimes aggressive tumor of major salivary glands, usually seen at birth and looks like primitary salivary development
- M=F, usually slow-growing,
- grosly multilobulated and at least a little circumscribed, sometimes c local invasion and hemmorhage, necrosis if higher grade
Px: recurs locally in 1/5
Squamous cell ca
Rare to have primary SCC of salivary gland, much more common to have mets from other site, esp direct extension from overlying SCC of skin
- HG non-K SCC can look like other salivary gland ca's, esp MEC
- can diff drom MEC c CK7, CK5/6 and mucicarmine (SCC is CD5/6 +, neg for CD7 and mucicarmine)
Salivary duct carcinoma
Rare (0-2% of salivary gland tumors) cancer of elderly (>50 yo) in parotid (possibly bilat), can look like DCIS of breast, but may actually come prom a other tumors (aka PA)
Micro: looks like invase ductal of breast, red cytoplasm, marked pleomorphism, vesicular nuclei, big nucleoli, looks like squames also can have Roman bridging
- can have calcification or necrosis or assoc c SCC
IHC:(+) androgen receptors (9/10), GCDFP, CKs, EMA, CEA, PCNA, inc Ki67
- neg: HER2 amplification (var), calponin, SMA, amylase, DOG1
Genes: diploid or aneuploid, 6q alteration, 17p/17q (less so than breast)
- chr 7 polysomy, 12q amplification, 9p LOH
Tx: excise, sample nodes, rads chemo
Px: if high grade can recur and infiltrate
- 1/2 survive at 5 yrs, worse if larger, mets, intraductal component, ER beta neg, p53+, HER2+, MMP9+, chr 7 polysomy
roman bridges in salivary duct ca

Salivary duct carcinoma, can look like ductal carcinoma of breast, has comedo necrosis


PLGA
%20salivary.jpg?crc=59079690)



Polymorphous Low-Grade Adenocarcinoma (PLGA)
- aka lobular ca or terminal duct ca
Only in minor salivary glands of mouth, usually the palate of adult females
Uniform cells in pleomorphic nests c bluish, bland round to spindly cells c ovoid vesicular nuclei and a hyaline/myxoid stroma (which lacks myoepithelial cells), c plump columnar tumor cells lined up in single file
- few mits, little necrosis, though perineural invasion is common it has no effect on px
Classically have whorling/sweeping cell arrangement along periphery, but architecture can be very variable
- can show targetoid pattern around vessels and nerves
Uninvolved (nonneoplastic) seromucinous glands tend to be more entrapped (not obliterated/effaced)
- similar to adenoid cystic carcinoma, may have stromal hyalinization
IHC (usually doesn't help too much): (+) S100, EMA
- variable CEA; weak c-kit
Tx: excision
Px: excellent, a low-risk malignancy
Mammary Analogue Secretory Carcinoma (MASC)
Tumor of the parotid c microcystic, papillary, and tubular patterns
- has a relation to acinic cell carcinoma and breast cancers, the genetics is mostly what makes it unique
- usually are slow growing lesions in the parotid of young males
- resembles secretory ca of the breast
IHC: (+) GCDFP-15, MUC1, BRST-2 and mammaglobin, CK, S100
- sometimes has (+) mucicarmine in intraluminal spaces
- negative HER2
Genetics: t(12;15)(p13;q25), ETV6-NTRK3 gene hybrid is diagnostic
MASC


Low-grade cribriform cystadenocarcinoma
IHC: (+) S100
Oropharyngeal Pathology
Normal Tooth Embryology (Odontogenesis)
Primary teeth start to form bwt 6th-8th WGA, permanent teeth in the 20th week
- the tooth germ is the aggregate of cells that form a tooth, derived from the ectoderm of the first pharyngeal arch and ectomesenchyme of the neural crest
-- tooth germ has 3 parts: 1) enamel organ; 2) dental papilla, 3) dental sac or follicle
1) Enamel organ - made of outer enamel epithelium, inner enamel epithelium, stellate reticulum and stratum intermedium
- these cells give rise to ameloblasts, which make enamel and become part of the reduced enamel epithelium (REE) after enamel maturation
- cervical loop is where the outer enamel epithelium and inner enamel epithelium join
2) Dental papilla - has cells that become odontoblasts (dentin-forming cells); the junction bwt dnetal papilla and inner enamel epithelium determines the crown shape of a tooth
- mesenchymal cells in the dental papilla responsible for the formation of tooth pulp
3) Dental sac (or follicle) gives rise to cementoblasts (form cementum of a tooth), osteoblasts (make alveolar bone around roots of teeth), and fibroblasts (develop periodontal ligament)
In normal teeth, tooth enamel made by the enamel organ, an ectodermally derived specialized epithelijm
- after enamel formation complete, enamel organ epithelium atrophies
-- the reduced enamel epithelium then merges c the overlying mucosal epithelium to form the initial gingival crevicular epithelium of the newly erupted tooth
Deciduous tooth - aka baby tooth or primary tooth; falls out during childhood
Succedaneous tooth - permanent tooth; aka adult tooth; replaces deciduous teeth and lasts throughout life normally
Normal Tooth Anatomy
4 types of teeth: incisors, canines, premolars, and molars
- each have their own function (incisors cut, canines tear, molars and premolars crush)
- the roots of teeth are embedded in the jaw bones (mandible and maxilla) and are covered by the gums
-- ameloblasts are specialized epithelial cells that form tooth enamel
--- enamel made of an inner layer of reduced / atrophied ameloblasts and an external layer most likely stratum intermedium cells
Juxtaoral organ of Chievitz (JOC)
normal anatomic structure found bilaterally at angle of mandible assoc c buccal n and buccotemporalis fascia
- can be mistaken for invasion of nerves of carcinoma, but is cytologically bland, lacking pleomorphism and has no mits
-- keratinization absent despite the presence of intracellular bridges
Pigmented (Melanocytic) Neuroectodermal Tumor of Infancy
Rare tumor of oral cavity and gums usually seen around birth, of neural crest origin (bc expresses melanotransferrin [involved in iron metabolism])
- grows rapidly, around midline or maxillary area
Micro: biphasic c melanin-containing cells and neuroblast-like cells
IHC: (+) S100, CK, HMB45, Melan A, NSE, CD57
Tx: excision
Px: B9, but can be locally aggressive and undergo malig changes
Mucocele
Mucus escape phenomenon, a pseudocyst from disruption of minor salivary glands, M=F, usually teens to early 20s, Mc on lower lip then bucal
Ranula = sublingual mucocele simple and plunging types
- Tyndall effect?
Histo: no true cyst wall, histiocytic response to mucus
Pyogenic granuloma / Lobular capillary Hemangioma
"Pregnancy tumor" - bump in preg womens mouth that resolves
Histo: can look dangerous at high power, but has thick vessels
Squamous papilloma
MC b9 tumor of oral cavity, exophytic epithelial neoplasm, branching fronds of squamous epithelium overlying fibrovasc cores, assoc c HPV, 40s to 50 yo, mostly on tongue and palate
Preneoplastic Squamous Surface Lesions
Criteria is different for keratinizing vs non-keratinizing ca's
- non-keratinizing is found more in cervix, not so much in upper aerodigestive tract (most are keratinizing; though this is confusing bc keratinization implies a degree of organization)
- lower-grade atypia is in lower 1/3, High grade atypia is in middle and upper thirds
Terms... (not to be used in path diagnosis)
Leukoplakia - white patch, low potential to progress to dysplasia
- other things that can present as a white patch: Candida, lichen planus, psoriasis, syphylis
- assoc c tobacco, EtOH,
Erythroplakia - red patch, has potential to progress to dysplasia
Erythroleukoplakia / Speckled leukoplakia -intermediate ca potential bwt red / white lesions
Hyperplasia - thickening of epithelial surface causing inc numbers of cells
Pseudoepitheliomatous hyperplasia (PEH) - can look cancerous but is just a very reactive / reparative epithelial overgrowth to some insult
- classically assoc c Granular Cell Tumor (GCT)
Keratosis - hyperkeratosis (inc surface keratin) c prominent granular layer and orthokeratin (anucleate keratin cells) usually c mixed parakeratin (flat keratinocytes c pyknotic nuclei)
- keratotic lesions w/o dysplasia do not usually turn into ca
Dysplasia = atypia
- cytologic and maturation problems
-- loss of polarity, nuc pleomorphism, inc mits, inc NC
- grading can be similar to cervix, as in mild, moderate or severe
-- severe dysplasia often multifocal and usually next to invasive lesions
- preinvasive lesions usually can be cured by stopping the insulting factor (tobacco)
- moderate dysplasia tells clinician that should FU closely
Carcinoma in situ - full-thickness mucosal atypia
Early / superficial / microscopic invasive SCC - SCC that has penetrated BM into submucosa
- can do BM stain to see if has invaded
- invasion of the seromucosal glands is CIS and not invasive
- dysfunction of vocal cords is muscle invasive
- microinvasive ca can either be part of CIS spectrum or can occur without full thickness atypia in "drop off" carcinoma
HPV+ Oral and Oropharynheal SCC
In young non-smokers c high risk behavior, are usually married and have a college degree; 19/20 HPV16+,
- wild type TP53, IHC p16
- non-K "basaloid" morphology, lobular growth pattern (not CIS)
- mod-poorly diff
- HV-related non-K SCC
- Cystic mets
Determining high-risk HPV status - gold standard is HR-HPV ISH for mRNA
Px: better c low T and high N stage tumors
- respond better to tx if HPV+ (?)
Papillary (exophytic) SCC
solitary exophytic lesion, M>F, older adults, in larynx (MC), oral mucosa, hypopharynx and sinonasal tract, possible assoc c HPV
- considered invasive even in absence of definite stromal invasion
Tx: surgical
Px: similar to conventional SCC; more of a b9 lesion even though is considered invasive (??)
-- ddx: should RO laryngeal papillomatosis
Inverted Papilloma
aka Schneiderian papilloma
see Nasopharynx (Respiratory)
Verrucous Carcinoma (VC)
Highly diff SCC variant that is not metastatic, but is locally destructive, also in older men, can occur anywhere in upper aerodigestive tract, but oral cavity MC, if in larynx is MC on glottis
Micro: broad base attachment, marked keratosis in layers (church-spire keratosis), no nuclear atypia, no mits beyond basal layer, pushing (not infiltrating) border, dysplasia limited to basal zone
- can look similar to papillary SCC, need lots of material
Tx: surgery (local or resection), but should not get rads
Px: excellent, rarely mets to local LN, distant mets not seen
Spindle Cell Squamous Carcinoma
- aka sarcomatoid carcinoma, carcinosarcoma, Lane tumor
Tumor with conventional SCC and malig spindle cell stromal components, older men, larynx (true > false vocal cords) more than oral cavity
- grossly polypoid / fungating mass
Micro: spindle cell stromal component usually more prominent and is hypercellular c pleomorphic large dark nuclei, lots of mits which can be variety of histologic patters (storiform, palisading, fascicular)
- necrosis not uncommon
- also has b9 or malig geterologous elements (bone or cartilage)
Px: generally poor (polyps less aggressive than flat lesions)
Basaloid SCC
Invasive, high-grade SCC variant with predisposition to hypopharnyx or base of tongue
- primary mucosal BCC is very rare
Hist: basaloid cells c wide variety of growth patterns; biphasic c surface dysplasia / conventional SCCA
- solid nests c central comedonecrosis, +/- peripheral palisading, highly atypical basaloid cells, pink hyaline droplets
- perineural or angiolymphatic invasion
IHC: (+) p63
Undifferentiated Carcinoma (Lymphoepithlioma-Like or Nasopharyngeal-Type)
Broken down into keratinizing and nonkeratinizing (both diferentiated and undifferentiated [includes lymphoepithelioma])
- uncommon in USA, but is ~1/5 of all cancers in China, M>F, MC in lateral wall (fossa of Rosenmuller)
- assoc c high EBV titers
- grossly can be either mucosal bulge
IHC: (+) keratins
Px: usually presents at advanced stage 2/2 location
- tend to met to LNs; undifferentiated type sens to rad
- 1/2 5-yr survival; depending on stage, pt age (younger the better), LN mets
Adenoid ("Acantholytic" or Angiosarcoma-like) SCC
MC in cutaneous sites of head and neck, less common from mucosal sites
- should be mentioned to avoid confusion c adenoCA
Micro: has pseudolumina that create appearance of glandular diff formed by acantholysis of malig squames
- true gland formation not seen (mucin stains neg)
IHC: (+) CKs and EMA
- neg: mucin, CD34 / 31, Factor VIII
Field cancerization
Carcinogen activation in entire exposed mucosa, c multiple separate ca's
- may start as a single site and spread laterally
- tobacco and EtOH are the most important risk factors
HPV Positive OP Ca
(+) HPV status in oropharyngeal carcinoma is strongly assoc c better therapeutic response and survival compared to HPV-negative carcinoma
Dentigerous Cyst
- aka follicular cyst, odontogenic cyst
2nd MCC of odontogenic cyst (~1/5 epithelium-lined jaw cysts), and the MCC of developmental odontogenic cyst; usually in young adults and teens
- assoc c crown of an unerupted (or partially erupted) tooth, usually the mandibular third molars (wisdom teeth)
- thought that the pressure from an erupting tooth on the follicle obstructs venous flow and causes an exudate to form bwt the reduced enamel epithelium and the tooth crown
- multiple simultaneous cysts are uncommon
- may be found on radiographs taken for delayed tooth rupture; usually painless, can be painful if infected; can be large enough to displace involved teeth and cause resorption of adjacent teeth
Imaging: usually a well-defined, unilocular radiolucency on X-ray c sclerotic rim (can look the same as KCOT and ameloblastoma)
Micro: cyst cavity lined by stratified squamous epithelial cells from reduced enamel epithelium of the tooth forming organ
- has no rete ridges, flat interface, lining epithelium 2-4 layers of cuboidal epithelium
DDx: Cystic ameloblastoma (usually has reverse polarization of nuclei [away from BM]); KCOT (has hyperchromatic basal palisading of cuboidal / columnar cells, and wavy surface parakeratosis)
Px: excellent, almost never recur c complete enucleation
Hyperplastic Dental Follicle
Odontogenic hamartomatous lesion assoc c delayed or failure of tooth eruption in young pts, usually first and second molars
Imaging: well-circumscribed radiolucent area c sclerotic borders surrounding the crown of an unerupted tooth
- frequently mimics a dentigerous cyst
- may also be mistaken for a odontogenic myxoma
Micro: fibrous connective tissue containing reduced enamel (odontogenic) epithelium, which is a layer of cuboidal to columar eosinopgilic cells that are the atrophic remnants of the effete enamel organ after dental crown formation complete
- wall of lesion made of fibromyxoid tissue
- also has multinucleated giant cells, and calcification foci
Lateral Periodontal Cyst (LPC)
- called a botyroid odontogenic cyst if multilocular
Non-keratinized and non-inflam developmental cysts found adjacent, lateral to, or bwt the roots a vital tooth/ teeth
- the cyst arises in the lateral periodontium or in the bone bwt the roots of erupted vital teeth
Micro: lining think c focal thickened plaque-like areas and variable cells cells, sometimes c swirling pattern in the thickened epithelium
Radicular Cyst
Associated with the periapex of a nonvital tooth and an inflammatory odontogenic cyst
Adenomatoid Odontogenic Tumor (AOT)
- aka adenoameloblastoma
Odontogenic tumor arising from enamel organ or dental lamina
- rare; seen in younger pts, 2F>1M; usually in anterior maxilla, and most are assoc c an impacted canine tooth
Imaging: radiolucency around an unerupted tooth extending past the cementoenamel junction
- usually has faint flecks of radiopacities surrounded by radiolucent zone
Gross: crown of tooth usually projects into cystic cavity
Micro: well-circ, central prolif of duct-like epithelium surrounded by small foci of calcification
- may see rosettes, trabecular or cribriform patterns of epithelium
- columnar-type cells c basal nuclei and clear cytoplasm can looklike pre-ameloblasts
- eosinophilic material seen in bwt tumor cells and in ductlike structures
Tx: enucleation
Calcifying Cystic Odontogenic Tumor (CCOT)
- aka calcifying odontogenic cysts, or Gorlin cyst
B9 odontogenic tumor of cystic type usually in the anterior areas of the jaws, usually in 2nd-3rd decade of life
- impacted tooth involved in ~1/3 of cases
- originally thought of as oral analogue to pilomatrixoma of skin
Imaging: unilocular radiolucency
Micro: "Ghost cells" are enlarged eosinophilic cells w/o nuclei that can calcify
- lined by stratified squames 2-3 cells thick
- focal areas of stellate reticulum-like cells seen
- near basement membrane can see ameloblast-like cells
3 types:
1) Type 1A Ghost cells and dentinoid
2) Type 1B formation of calcified tissues in lumen of cyst wall --> dystrophic calcification
- prolif of tissue similar to ameloblastic fibroma
3) Type IC Ameloblast-like prolif in the connective tissue and lumen of cyst can be seen
Tx: enucleation and curettage
Keratocystic Odontogenic Tumor (KCOT)
- previously odontogenic keratocyst (OKC) but renamed 2/2 potential for aggressiveness, recurrence and genetic abnormalities
Parakeratin lined cyst-like tumor in bone (posterior mandible), ~1/10 of odontogenic cysts, MC up to 30 yo; 9/10 solitary
- multiple tumors assoc c Gorlin syndrome (nevoid basal cell carcinoma syndrome [NBCCS])
- may arise from dental lamina; usually cause jaw swelling
- grossly has thin wall c unerupted tooth
Micro: uniform epithelium of palisading hyperchromatic basal cell cuboidal to columnar cells w/o rete ridges
- luminal side c wavy "corrugated" parakeratotic epithelial cells and can have keratotic debris inside
Genes: 2-hit mech in bi-allelic loff of PTCH ("patched") tumor suppressor on 9q22.3 causing dysregulatio nof p53 and cyclin D1 oncoproteins
Tx: decompression , enucleation, excision (may be excessive)
Px: up to 1/2 recur (possibly 2/2 daughter cysts in the wall that are not excised, or fragmentation of the cyst wall during excision)
Ameloblastoma
Rare tumor of sinonasal tract (though MC clinically significant odontogenic tumor); found in maxillary sinus extended from maxilla; MC in older men (60 yo); previously adimantinoma
- no known etiology; possibly arises from remants of ameloblast or dental lamina, dentigerous cysts or basal layer or oral mucosa
- solid and cystic grossly; MC in posterior mandible
Micro: columnar basal cells in palisading configuration c vacuolated cytoplasm and hyperchromatic nuclei polarized away from BM (reverse polarity)
- suprabasal cells loose / not cohesive; similar to stellate reticulum
- no enamel or dentin formation
- can have follicular and plexiform patterns
Px: grows slowly, can recur, may met but wont kill
Ameloblastic Carcinoma

Tooth bud: A - enamel organ, B - dental papilla, C - Dental follicle



Tooth erupting into mouth; A-tooth, B-gingiva, C-bone, D-periodontal ligaments
Bone resection c pigment below surface in a Pigmented (Melanocytic) Neurocetodermal tumor of infancy

Pigmented large epithelioid cells c smaller primitive cells
Smaller primitive cells in nests

Leukoplakia


Erythroplakia

Dentigerous cyst




Dentigerous cyst lined b thin layer of stratified squames c chronic inflam in stroma



Hyperplastic Dental Follicle
LPC



Radicular cyst, c epithelial lining c arcaded pattern c iinflam

AOT c fibrous connective tissue capsule (*), nodular aggs of cells (#), and duct-like strucures (->)

Gland-like spaces surrounded by cuboidal to columnar cells (->)
AOT


CCOT with calcification of ghost cells

Keratocystic Odontogenic Tumor (KCOT)

Ameloblastoma c islands c palisaded nuclei c reverse polarization and subnuclear vacuolization




Ameloblastoma

Ameloblastic Fibroma (AF)
Occur up to 20 yo;
- ameloblastic fibroma (AF) and ameloblastic fibro-dentinoma occur at later ages than ameloblastic fibroodontoma (below)
Micro: b9 odontogenic c pallisading nuclei c subnuclear vacuoles, and fairly b9 lookiing stroma
Ameloblastic Fibro-Odontoma (AFO)
Rare, mixed odontogenic tumor
- usually seen up to 20 yo (but can occur at any age), while ameloblastic fibroma (AF) and ameloblastic fibro-dentinoma occur at later ages
Micro: b9 amyloblastic epithelium with primitive ectomesenchymnal stroma
Amyloblastic Fibrosarcoma
Rare; M>F, 20-30 yo; present c swelling and pain; found in mandible and can extend to maxillary sinus; mixed odontogenic tumor made of b9 amyloblastic epithelium and malignant mesenchymal stroma
- possibly related to ameloblastic fibroma
- called ameloblastic fibroodontosarcoma if enamel seen in malig stroma
Imaging: expansive, multilocular radiolucent lesion c cortical perforation
Micro: biphasic c b9 ameloblastic epithelium and malig spindly stroma
- b9 amloblastic epithelium c palisading, reverse polarization, stellate reticulum-like material
- malig stroma is hyperchromatic, pleomorphic, inc mits, can have herringbone / storiform pattern
Tx: surgery c wide margins; may use adjuvant chemo-rads
Px: locally agressive, ~1/2 recur
- can have distant mets
Odontoma
MC odontogenic tumor, usually asx
- generally assoc c trauma during primary dentition, and also inflam and infx processes, hereditary anomalies (Gardner syndrome, Hermann syndrome), odontoblastic hyperactivity
Tx: curettage
Compound Odontoma
Regularly calcified tissue similar to teeth or a small collection of teeth, and are considered to be hamartomas
- composed of tissue native to teeth: enamel, dentin, cementum and pulp tissue
- seen in first 2 decades of life, esp 14-18 yo, MC in anterior maxilla; may inhibit eruption of teeth
Imaging: multiple tooth-like structures
Micro: tooth-like structures arranged in uniform manner similar to normal tooth
- enamel matrix looks like fish scales; also has remnants of enamel origin and tubular dentin
Ddx: supernumerary teeth (are usually normal-sized teeth)
Complex Odontoma
Conglomeration of dentin, enamel and cementum
Micro: tooth components mixed and disorganized
Cystic Odontoma
asdf
Cherubism
Abnormal bone tissue in lower part of face, lower and upper jaw become enlarged c cyst-like growths starting in early childhood
- rounded, swollen cheeks interfere c normal tooth development
- usually stabilizes during puberty, and growths are replaced c normal bone, and can have a normal face by adulthood
- may occur c Ramon syndrome (intellectual disability, short stature, gingival fibrosis) or Noonan syndrome, fragile X syndrome
Imaging: multiple bilateral multilocular radiolucencies
Micro: a helpful feature is eosinophilic cuffing of blood vessels
Genes: mutated SH3BP2 found in ~4/5
Central Giant Cell Granuloma (CGCG)
- formerly called giant cell reparative granuloma
b9 condition of jaws, usually on anterior part of the mandible and cross the midline
- 2F>1M, in 20-40 yo, usually larger lesions that can move teeth and resorb roots
- thought to be two forms: aggressive (grows quickly and more likely to perforate cortical plate) and non-aggressive (grows slowly)
Imaging: multilocular radiolucency of bone c scalloped margins though still well-demarcated
Micro: lots of MNGCs (probably osteoclasts) found diffusely or locally in stroma of plump uniform mononuclear mesenchymal cells often c extravasated erythrocytes and hemosiderin deposits
- giant cells either large and round or small and irreg
- can have hemosiderin deposits
DDx: KCOT, ameloblastoma, odontogenic myxoma, hyperparathyroid tumor, cherubism
Peripheral Giant Cell Granuloma (PGCG)
seen in mouth, is an overgrowth of tissue 2/2 infx or trauma
- usually assoc c pyogenic granuloma and peripheral ossifying fibroma (all are causes of a "bump on the gum")
- F>M, usually around 50-60 yo, MC on the mandible and can be ant or post, can destroy underlying alveolar bone
- thought by some to be a soft tissue equivalent of central giant cell granuloma bc of microscopic similarity
Gross: bluish to red, <2 cm, pedunculated
Micro: large numbers of multinucleated giant cells, c a ovoid to spindly stroma
- can have hemosiderin and hemorrhage near the borders
- ulcerations occur in 1/2
Tx: excision
Pyogenic Granuloma
- a cause of a "bump on the gum"
see Blood Vessels
Fibrous Hyperplasia
Swellings caused by overgrowth of fibrous connective tissue in response to chronic trauma
- can be 2/2 plaque or calculus, orthodontic appliances, over-extended or ill-fitting dentures, malocclusion
- clinically looks pale and same color as surrounding mucosa
Micro: unencapsulated, solid, nodular mass of dense and sometimes hyalinized fibrous connective tisue
- surface epithelium usually atrophic but can have sign of continued trauma, like inc keratin, intracellular edema and traumatic ulceration
DDx: giant cell fibromaddd
Tx: surgical excision, and removing the source of trauma
(Cemento-) Osseous Dysplasia
Oseeous Dysplasia / Cemento-Osseous Dysplasia (OD/COD [the 2 terms are synonymous]) comes in 3 flavors:
1) periapical OD/COD - dysplastic lesions in anterior mandible involving only a few adjacent teeth
- common in those of African descent
2) focal OD/COD - similar to periapical OD/COD, but c limited number of lesions in posterior jaw quadrant (rather than anterior mandible)
- common in Caucasians
3) florid OD/COD and familial gigantiform cementoma - more extensive forms, usually bilateral in mandible or in all jaw quadrants
- common in those of African descent
MC in women in their 40-50's yo
Tx: no tx necessary
- must get the right tx so doctor does not confuse c rarefying osteitis or condensing osteitis and perform unnecessary root canals
Odontogenic Myxoma
Rare intraosseous neoplasm; presenting as a slow-growing, expansile, painless, central tumor of the jaw; usually in 2nd-3rd decades
- thought to be derived from mesenchymal portion of the tooth germ
Imaging: multilocular radiolucency, c well-developed locules c fine trabeculae arranged at right angles known as "Tennis-raquet" or "step-ladder" pattern
Micro: loosely arranged stellate-shaped cells c intermingled fibrillar processes in a homogenous mucoid ground substance
DDx: the dental papilla of a developing tooth bud may be confused with an odontogenic myxoma if taken out of context
Px: b9 but locally aggressive
Central Odontogenic Fibroma (COF)
Very rare; no sx, expansile cortical plate of mandible or maxilla
- prolif of mature odontogenic mesenchyme, possibly of peridontal ligament origin; 3F>1M
Imaging: unilocular or multilocular radiolucency, that may look similar to ameloblastoma
Micro: mature collagen fibers c lots of plump fibroblasts that are uniform and equidistant from one another
- small nests / islands of odontogenic epithelium that appear inactive are present in small amts
DDx: odontogenic myxoma with fibrous features (fibromyxoma)
- ossifying fibroma with few bony or cementum-like components
Tx: enucleation and curettage
Cemento-Ossifying Fibroma
Fibro-osseous jaw lesion thought to arise from periodontal ligament, and are made of differing amts of cementum, bone and fibrous tissue
Px: continues to grow to enormous size and can deform the face if not treated
Peripheral Ossifying Fibroma
- aka fibrous epulis containing bone (term used in the UK)
Gingival nodule made of a cellular fibroblastic connective tissue stroma assoc c formation of randomly dispersed foci of mineralized products, such as bone, cementum-like tissue or dystrophic calcification
- considered to be part of an ossifying fibroma, though thought to be a gnathic tumor
- assoc c pyogenic granuloma and PGCG (all are causes of a "bump on the gum")
-- the term "peripheral ossifying fibroma" criticized bc lesion is not related to an ossifying fibroma of bone, and is not a fibroma
- F>M, can be pedunculated or sessile
Micro: combination of mineralized product (such as trabecular bone formation) and fibrous proliferation
- more highly developed bone or cementum likely to be present when the lesion has been there for a longer period of time
Tx: excision
Px: high rates of recurrence
Medication-Related Osteonecrosis of the Jaw (MRONJ)
Relatively uncommon, but serious side effect of tx c anti-resorptive agents like IV high-potency bisphosphonates and denosumab
- is a side effect of cancer therapies that target angiogenesis
- a major risk factor is dento-alveolar surgery
- by definition is exposed bone in the maxillofacial region that does not heal in 8 weeks
- may be 2/2 oversuppression of bone resorption, inhibition of blood supply, constant microtrauma, and infx
AFO, follicles of ameloblastic epithelium c primitive ectomesenchyme

AFO c areas of enamel and dentine in close relationship c ameloblastic epithelium



AF
AF
Ameloblastic fibrosarcoma
Ameloblastic fibrosarcoma b9 epithelial part with maligannt stroma



Ameloblastic fibrosarcoma c malig stroma c inc mits (red arrow) and b9 emlyoblastic epithelium (lower left)
Complex odontoma
soft tissue attachment c odontoma
deciduous tooth

Compound odontoma
Complex odontoma - disorganized mineralized mass of dentin enclosing enamel spaces c specks of enamel matrix; pulp-like tissue also seen


Attachment of complex odontoma c deciduous tooth


Cherubism

CGCG


PGCG


Fibrous hyperplasia


Focal Fibrous Hyperplasia (FFH)
Periapical OD/COD
Florid OD/COD


Odontogenic Myxoma

COF c loose stroma c fine collagen fibrils and small odontogenic epithelial rests (arrows)

Dense fibrous stroma c vague whorling pattern and focal calcifications (arrows), characteristic of the variant referred to as the WHO type (subclassification being phased out)

Cemento-Ossifying Fibroma

Peripheral Ossifying Fibroma


MRONJ


References
Anatomy and Histology
1. Dr. Said notes
2. https://embryology.med.unsw.edu.au/embryology/index.php/Salivary_Gland_Development
3.
Inflammatory Salivary Disease
1.
Benign Salivary Tumors
1. Pathology Outlines Case #375. http://pathologyoutlines.com/caseofweek/case375.htm?utm_source=COW+%23375&utm_campaign=Case+%23375&utm_medium=email
2.
Malignant Salivary Tumors
1.
